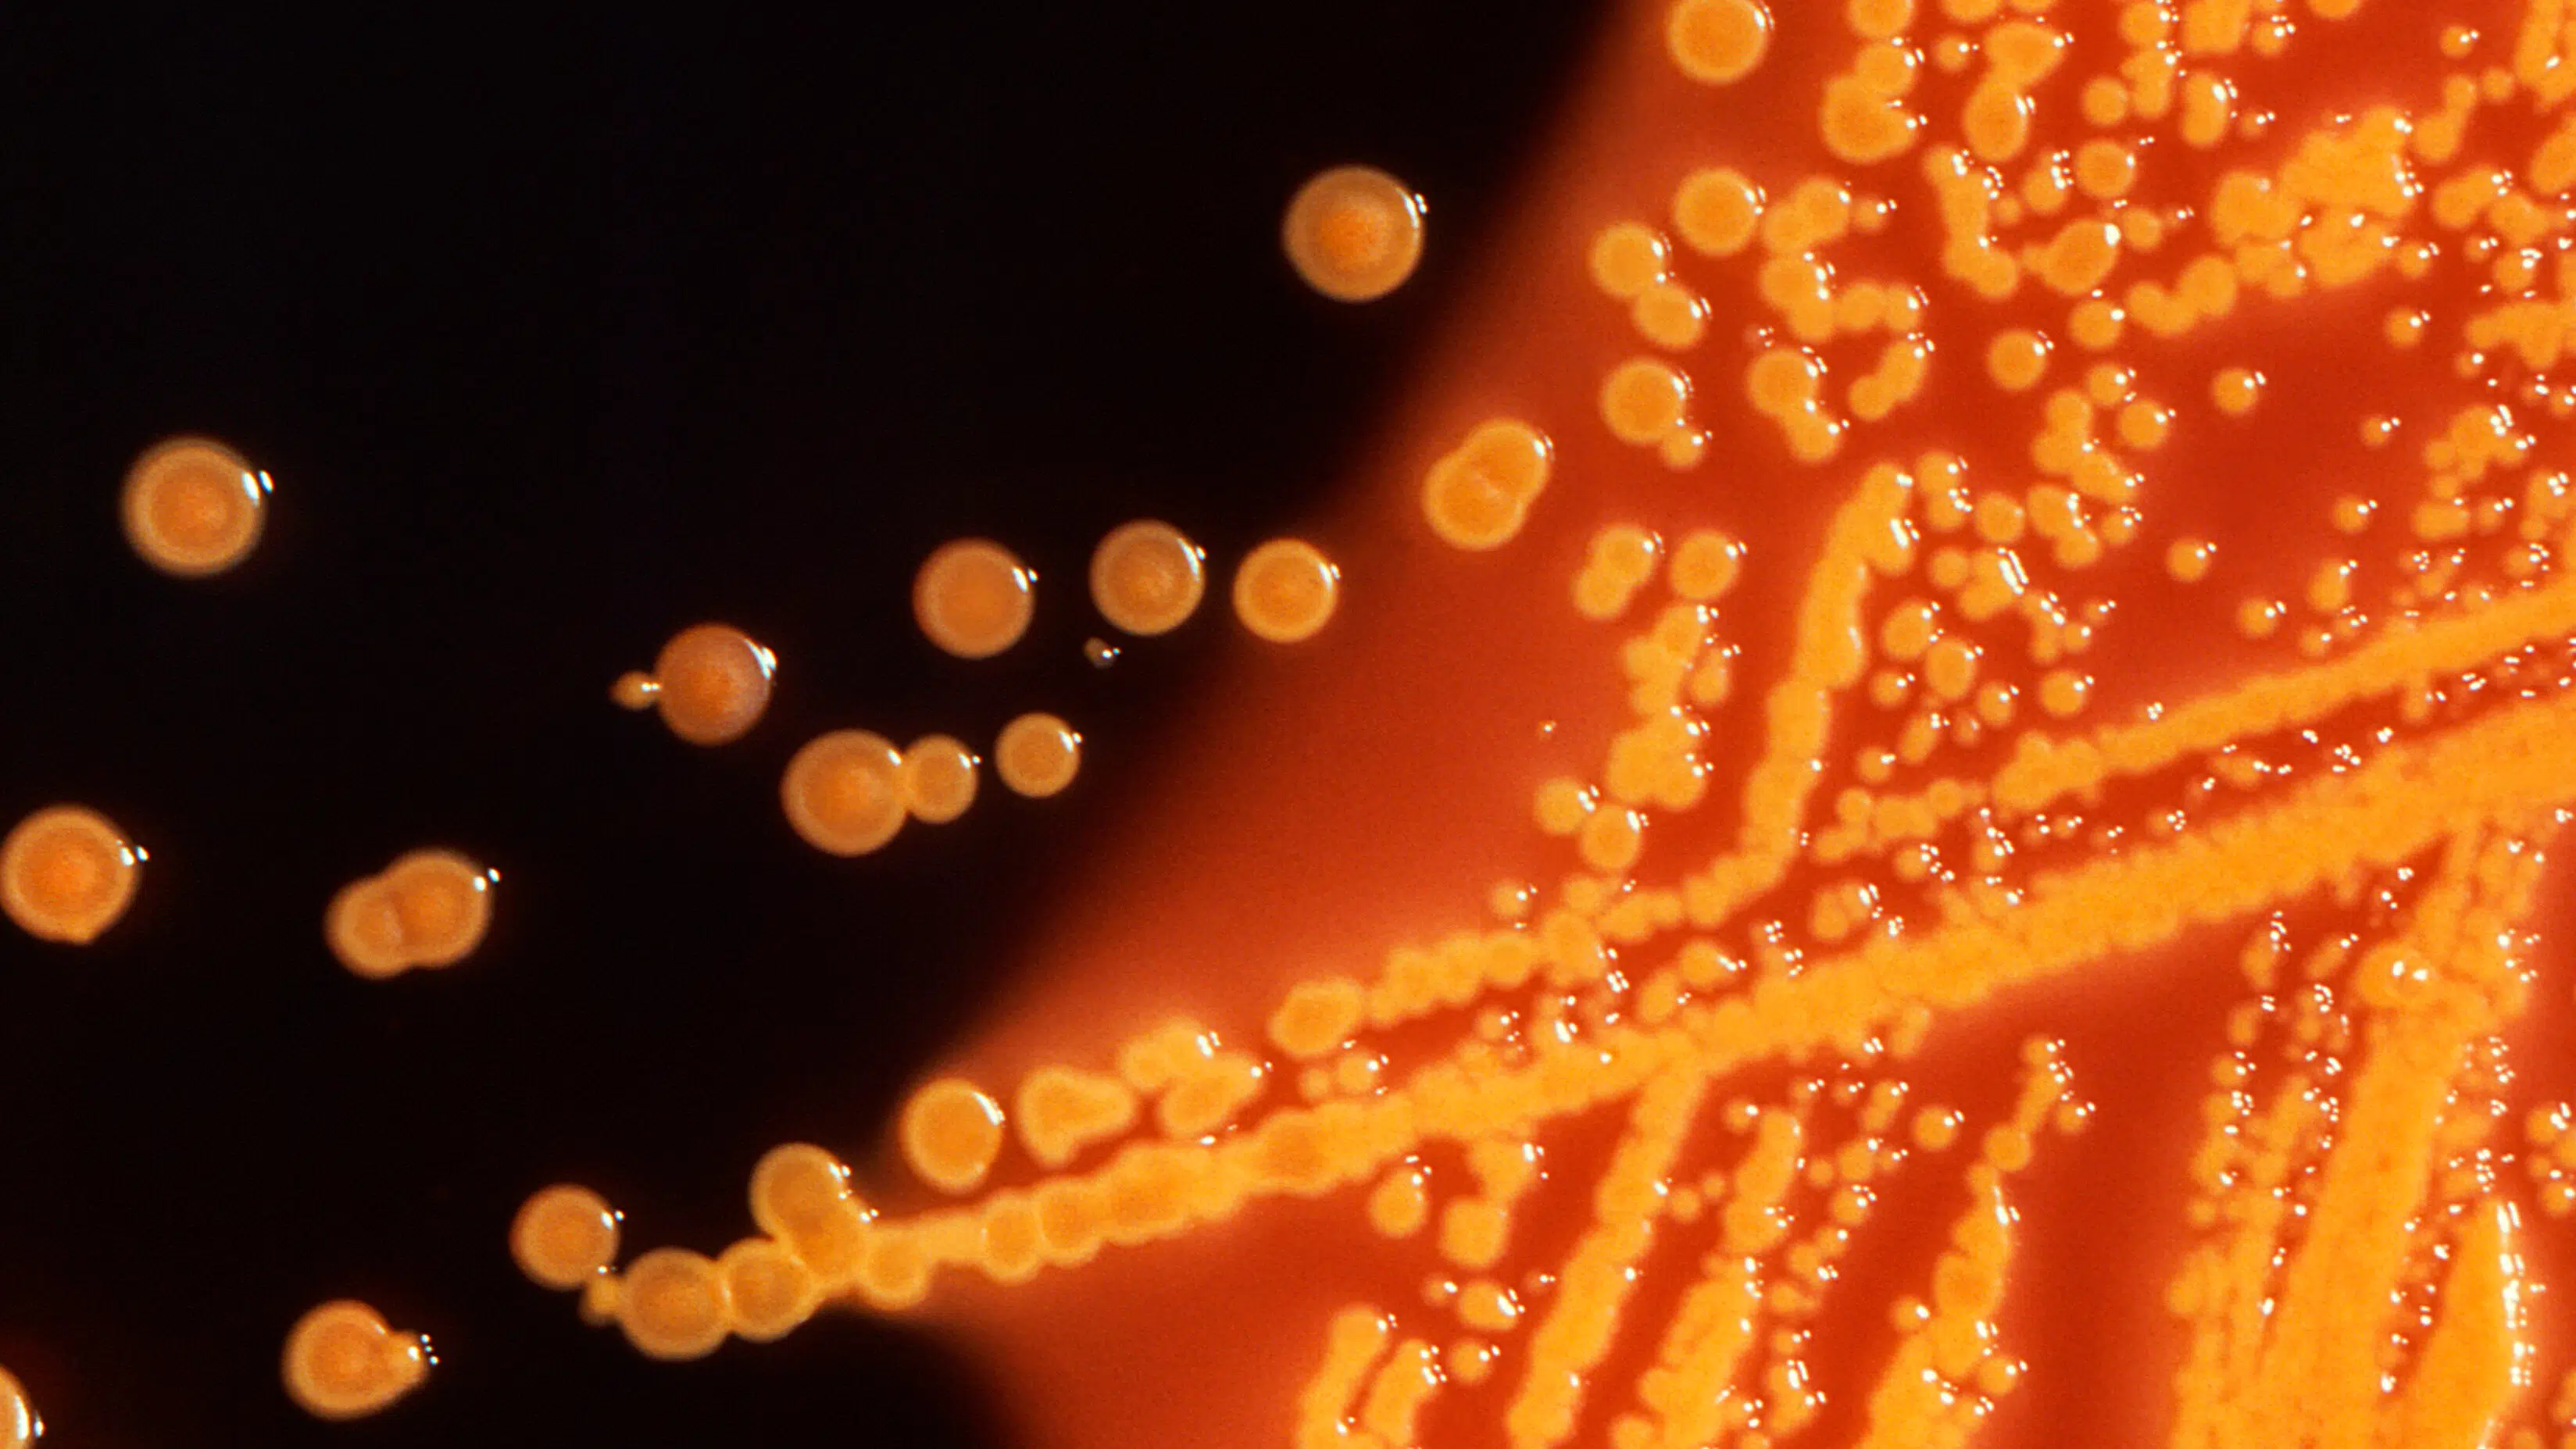

USA's højesteret afviser konspirationsteoretikers anke i milliard-sag
Amerikaneren har tidligere argumenteret for, at den oprindelige dom brød med hans ytringsfrihed.

Amerikaneren har tidligere argumenteret for, at den oprindelige dom brød med hans ytringsfrihed.

Amerikaneren har tidligere argumenteret for, at den oprindelige dom brød med hans ytringsfrihed.
Midt i en travl ministerhverdag i København prøver Stephanie Lose altid at tage hjem til Esbjerg i løbet af ugen. Det er en måde at føle sig tættere på familielivet derhjemme, fortæller økonomiministeren – også selv om det bare er i et par timer.
Midt i en travl ministerhverdag i København prøver Stephanie Lose altid at tage hjem til Esbjerg i løbet af ugen. Det er en måde at føle sig tættere på familielivet derhjemme, fortæller økonomiministeren – også selv om det bare er i et par timer.
Robert Frosts digte er både gammeldags og fra en fremtid, der endnu ikke er begyndt. Nu ligger de i en oversættelse, som virkelig kræver respekt.
Robert Frosts digte er både gammeldags og fra en fremtid, der endnu ikke er begyndt. Nu ligger de i en oversættelse, som virkelig kræver respekt.

Stadigt flere afspiller musik, videoer eller har private samtaler på medhør i den kollektive transport. Det skyldes en opløsning af skellet mellem det private og det offentlige og et skred i koderne for, hvilke lyde man bør udsætte andre for

If you take Danish property ads at face value, you might find yourself waist-deep in renovation bills or disappointed with your new locality. Out guide will help you read between the lines.
Læger forventer, at vi i fremtiden vil se markant flere dø af bakterier, som er resistente overfor medicin.

Officielt har han ikke et pas til det land, som han har regeret i 11 år, men det er langt fra hans største problem.

Officielt har han ikke et pas til det land, som han har regeret i 11 år, men det er langtfra hans største problem.

En medarbejders fejldisponering sendte kemiaffald i Kobber Å og dræbte fisk på en lang strækning.

"Den sidste viking" og "Ternet Ninja 3" kan få nomineringer til European Film Awards.

»Søforklaringer« fra en række pensionskasser, et økonomisk eksperiment og Elon Musk, der presser et dansk selskab. Det er blot nogle af overskrifterne i dagens Update fra Berlingske Business.
Efter festen for de overlevende gidslers frigivelse kommer kritikken af, at ligene af dræbte israelere fortsat er i Gaza.
Efter festen for de overlevende gidslers frigivelse kommer kritikken af, at ligene af dræbte israelere fortsat er i Gaza.